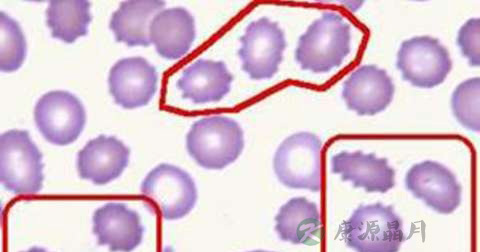

黄疸是由于血清中胆红素升高致使皮肤、巩膜及黏膜发黄的症状和体征。新生儿出生24小时后血清胆红素由出生时的17~51μmol/L(1~3mg/dl)逐步上升到86μmol/L(5mg/dl)或以上临床上出现黄疸而无其它症状,1~2周内消退,这种情况被称为溶血性黄疸。一般黄疸为轻度,呈浅柠檬色,急性溶血时可有发热、寒战、头痛、呕吐、腰痛,并有不同程度的贫血和血红蛋白尿(尿呈酱油色或茶色),严重者可有急性肾功能衰竭。慢性溶血多为先天性,除伴贫血外尚有脾肿大。

溶血性黄疸是可以治好的,这类疾病治疗方法比较多,常见就是药物治疗,在对患者溶血性黄疸改善上,都是有着很好帮助作用。
2.1、光疗:患儿暴露于波长440nm的光线下能使血清胆红素下降,防止核黄疸的发生,如核黄疸已经发生则可使其恢复快一些。经这种光线照射后,胆红素被光氧化变成无色物质,从尿和胆汁排出体外。这种治疗简便易行,有一定疗效。一种简便的方法是将40W蓝色荧光管7支作为光源。将患儿置于保温箱中,除去衣服及尿布,用黑眼罩(纱布裹黑纸)遮盖双目。将光源置于离体表33~35cm处,每小时改变一次体位以增加光照面积。光照时间大多为24~48小时,最长可达96小时。治疗过程中要注意液体补给(以防脱水)和护肝治疗。经这种治疗,皮肤黄疸消退和血清胆红素下降均较快。
2.2、输血:血清间接胆红素如超过20mg/dl(342μmol/L),需采用换血输血。供血者须先作G6PD缺乏的过筛试验,必须没有G6PD缺乏方可供血,以免输血后加重和黄疸。避免亲属供血。黄疸不严重者不需输血。

治疗溶血性黄疸的费用因人制宜,因地制宜,建议在与医生的沟通下治疗。同时还应积极提高自身抵抗力,防治并重,这样才有可能彻底治愈溶血性黄疸。
1、黄疸一般多见于肝胆疾病引起的胆红素阻塞不宜排出,猪油含有大量的脂肪,消化需要胆汁的乳化,加重肝胆的负担,容易加重黄疸的症状,不利于恢复。宜吃低脂的食物。
2、辣椒属于刺激性的食物,容易刺激缓激肽,组胺物质释放,可能会加重黄疸的症状,不利于患者的恢复。宜吃清淡的食物。
3、白酒还有大量的酒精,酒精可以刺激损伤肝脏细胞,加重胆红素代谢障碍,加重黄疸的症状,不利于患者的恢复。宜吃不含酒精的饮料。
豫公网安备 41110202000246号互联网药品信息服务资格证书:(豫)-经营性-2022-0039增值电信业务经营许可证:豫B2-20221313医疗器械经营备案编号:豫郑食药监械经营备20212188号



